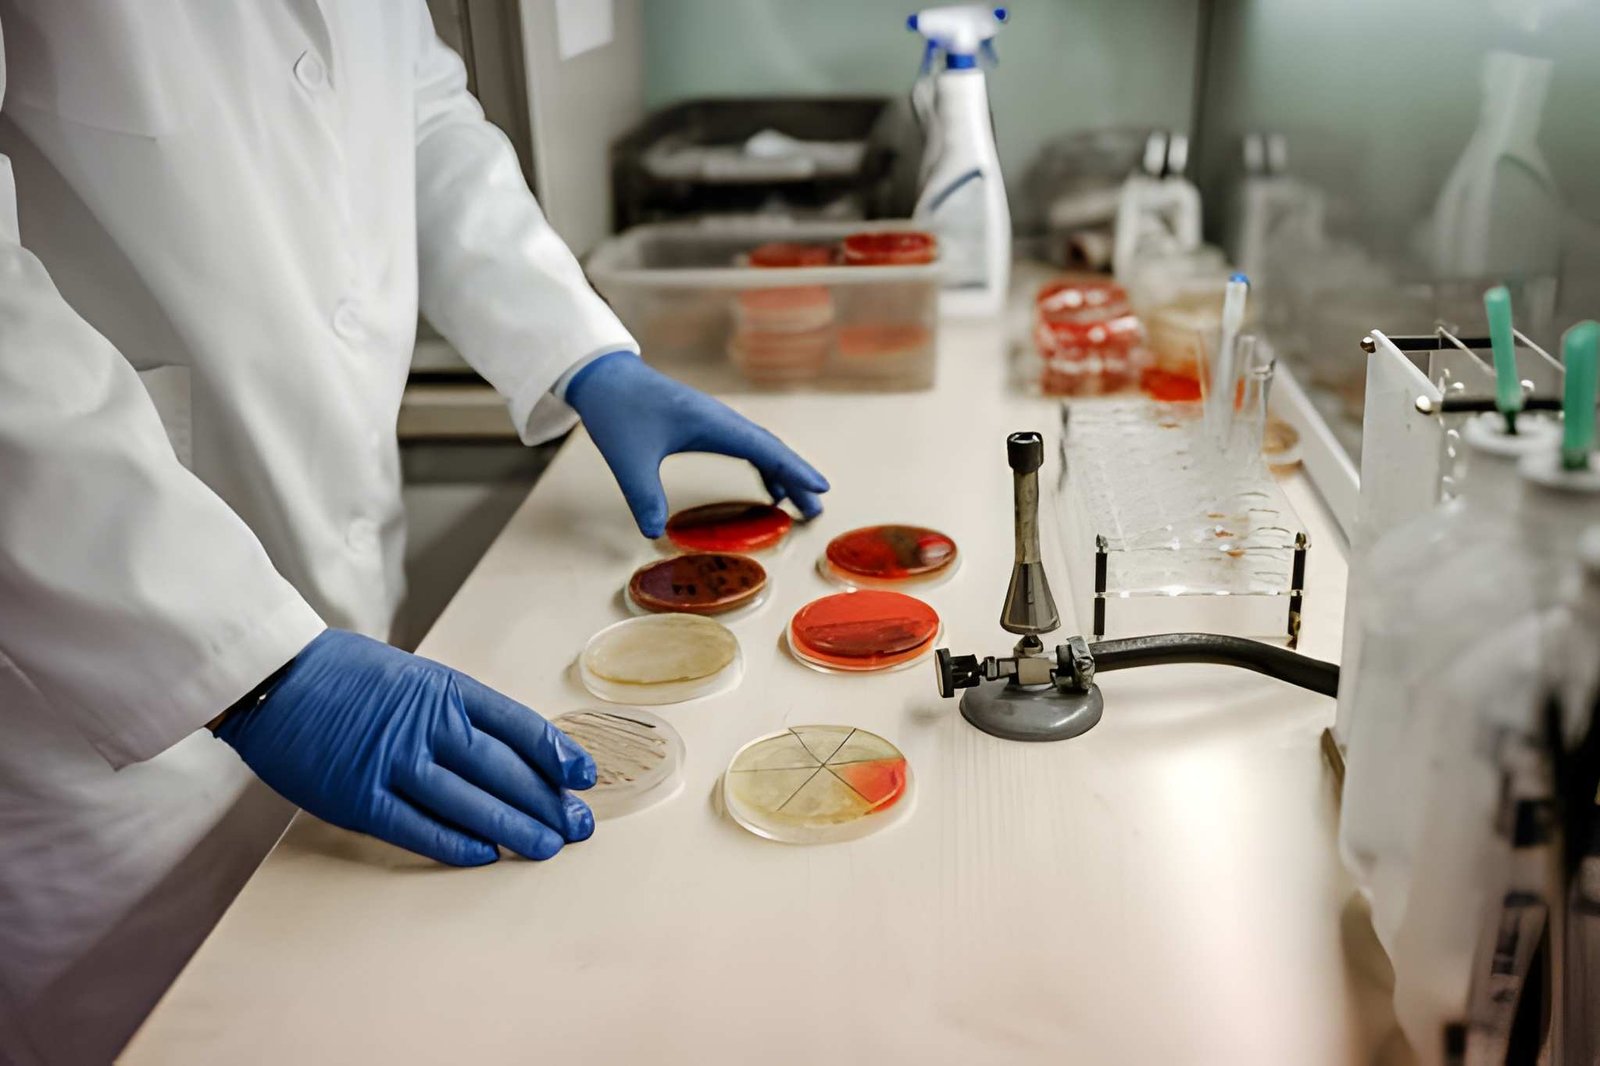
Infectious ,<br> <span>Disease Control Training</span>

Practices Through Intelligence

Medical/Dental ,
Coding/Billing & more
Disease Control Training


AR Follow up
Digital Marketing
Chronic Care
Our Services
Empowering Businesses, Elevating Outcomes
- 99% success rate
- Professional Experts
- quality service
- World-wide Clients
Our team Works closely with you to ensure that our Services scale with your growth.
Trusted By Top Companies






Your growth is our mission and your success is our benchmark.
We Strengthen Your Financial Performance
From AR follow-up to data optimization and analytics, we take a proactive approach to revenue improvement.
In today’s healthcare landscape, every dollar matters but many practices lose revenue due to delayed collections, claim denials, inaccurate coding, and inefficient billing workflows. Naviums eliminates these obstacles by taking complete ownership of your revenue lifecycle, empowering you to focus on patient care while we maximize your financial outcomes.
Recover aging receivables faster.
We Enable Operational Efficiency Without Increasing Overhead
Our Virtual Support Services, PMS/EHR implementation expertise, and structured project management allow you to scale seamlessly without adding unnecessary staff or administrative burden.Healthcare organizations are under constant pressure more patients, more administrative work, stricter compliance, and rising staffing costs. Naviums removes that pressure by giving your practice the tools, support, and structure needed to operate efficiently without hiring more in-house staff or overwhelming your current team.
We combine Virtual Support, Workflow Optimization, and Project & Technology Enablement to streamline every level of your operations.
We Transform Data Into Actionable Intelligence
With our structured data services, analytics frameworks, and chronic care management support we empower smarter decision-making across your organization.Data that informs decisions. Insights that drive results.
Most healthcare organizations generate massive amounts of data but lack the time, structure, or tools to use it effectively. Inaccurate data, fragmented systems, and outdated reporting prevent leaders from making confident decisions that support both clinical outcomes and operational performance.
At Naviums, we turn raw data into a powerful strategic asset.


Trusted By









Smart and Great Solution for Your Business
If You Have Any Questions? Get In Touch
Comprehensive Support
End-to-end service covering information gathering, submission, follow-ups, and communication
24/7 Access
Monitor your Work status anytime, anywhere through our online platform
Peoples Talk About Naviums




Our Latest Blog & News
Hello world!
Attract and retain quality high paying customers
A day in the life of entrepreneur & ceo
Bring to the table win-win survival strategis
Future where technology creates good jobs
What you do today improve your tomorrows
Trusted By Top Companies
































